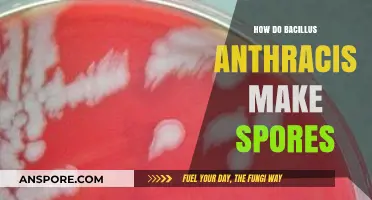
Unveiling Bacillus Anthracis: The Intricate Process of Spore Formation

In the game *Spore*, befriending the Grox, a highly aggressive and advanced alien species, presents a unique challenge for players aiming to achieve the Diplomat badge or simply to explore peaceful interactions in the Space Stage. The Grox are notorious for their hostility, controlling a significant portion of the galaxy and attacking on sight, making diplomacy with them a daunting task. To befriend the Grox, players must employ a combination of strategic planning, resource management, and careful interaction. This typically involves locating their empire, avoiding direct confrontation, and using gifts of Sporebucks or valuable items to gradually improve relations. Additionally, players can leverage tools like the Analyzer and terraforming abilities to demonstrate non-hostile intentions and gain their trust. Successfully befriending the Grox not only unlocks unique rewards but also showcases a player’s ability to navigate complex interstellar diplomacy in the face of overwhelming odds.
| Characteristics | Values |
|---|---|
| Game | Spore |
| Species Involved | Grox |
| Player Species | Any (but must be in Space Stage) |
| Primary Goal | Befriending the Grox |
| Grox Behavior | Initially hostile, highly aggressive |
| Key Strategy | Use diplomacy and gifts |
| Required Tools | Spice (resource), Trade Tool |
| Spice Requirement | Large amounts (exact quantity varies) |
| Trade Tool Usage | Offer Spice to Grox empires |
| Relationship Improvement | Gradually increases from Hostile to Allied |
| Benefits of Alliance | Protection, access to Grox technology |
| Risks | High chance of failure, potential for war |
| Alternative Methods | None (diplomacy is the only way) |
| Difficulty Level | Very High |
| Time Investment | Significant (due to resource gathering and repeated attempts) |
| Community Tips | Save often, prepare for multiple retries |
| Latest Patch Impact | No recent changes affecting Grox diplomacy |
Explore related products
What You'll Learn
- Understanding Grox Behavior: Learn their patterns, preferences, and triggers to approach them safely
- Using Gifts: Offer resources like Spice or rare items to gain their trust
- Non-Aggressive Stance: Avoid attacking or provoking them to maintain peaceful relations
- Diplomatic Tools: Use the Befriend or Ally options in the game interface effectively
- Alliance Benefits: Leverage Grox alliances for protection and access to their territories

Understanding Grox Behavior: Learn their patterns, preferences, and triggers to approach them safely
The Grox, the formidable empire in *Spore*, are not your typical allies. Their aggressive nature and advanced technology make them a daunting presence in the galaxy. However, understanding their behavior is the first step toward befriending them. Observing their patterns reveals that they are highly territorial and respond predictably to certain stimuli. For instance, they often attack unprovoked when you enter their space, but their aggression diminishes if you demonstrate strength or compliance. This suggests that their behavior is rooted in dominance and respect for power. By studying these patterns, you can identify opportunities to approach them without triggering hostility.
To safely interact with the Grox, it’s crucial to learn their preferences and triggers. They favor displays of technological prowess and military strength, often interpreting advanced spacecraft and weapons as signs of respect. Conversely, they are quick to attack weaker or less advanced civilizations, viewing them as threats to their dominance. A practical tip is to upgrade your ship’s weapons and armor before entering Grox territory. Additionally, avoid aggressive actions like firing first or invading their planets, as these will escalate their hostility. Instead, focus on passive interactions, such as trading or gifting resources, to signal your peaceful intentions.
A comparative analysis of successful Grox interactions reveals a common strategy: gradual exposure. Start by approaching the outer edges of their territory, where their patrols are less frequent. Over time, as they become accustomed to your presence, you can venture deeper. This method mirrors animal behavior studies, where gradual desensitization reduces fear and aggression. For example, if you’re playing with a younger audience (ages 10–14), explain this as “slowly making friends with a grumpy neighbor by being nice and not bothering them too much.” Patience is key, as rushing the process can lead to catastrophic consequences.
Finally, understanding the Grox’s triggers is essential for survival. Their primary trigger is perceived weakness, so avoid entering their territory with low health or inadequate defenses. Another trigger is proximity to their core worlds, which they guard fiercely. A useful tactic is to map their territory using probes or allies’ intelligence, identifying safer zones for initial contact. If you accidentally provoke them, retreat immediately and reassess your strategy. Remember, befriending the Grox is not about changing their nature but adapting to it. By mastering their behavior, you can turn one of the galaxy’s greatest threats into a powerful ally.
How Do Vascular Plants Reproduce? Exploring Spore-Based Reproduction Methods
You may want to see also

Using Gifts: Offer resources like Spice or rare items to gain their trust
In the intricate dance of interstellar diplomacy within *Spore*, the Grox, with their formidable reputation, present a unique challenge for any empire seeking alliance. One proven strategy to thaw their cold demeanor is the strategic use of gifts, particularly resources like Spice or rare items. These offerings serve as tangible symbols of goodwill, bridging the gap between species and fostering trust where suspicion might otherwise reign.
Consider the mechanics of gift-giving in *Spore*: the value of a resource is not just in its rarity but in its relevance to the recipient. Spice, for instance, is a coveted commodity across the galaxy, often used to fuel economies or enhance trade. Offering a substantial quantity—say, 500 units—can signal both generosity and an understanding of the Grox’s priorities. Rare items, such as artifacts or unique minerals, carry a similar weight, as they demonstrate effort and foresight in anticipating their needs.
However, the act of giving is not without risk. The Grox are not easily swayed by superficial gestures. A poorly timed or insufficient gift can backfire, reinforcing their perception of weakness or insincerity. To mitigate this, pair your offerings with diplomatic actions, such as avoiding aggressive posturing or aligning with their allies. Think of it as a multi-pronged approach: gifts open the door, but consistent respect and strategic alignment keep it from slamming shut.
For those new to this tactic, start small and observe their reaction. Begin with a modest gift of 100 Spice units or a single rare item, then gauge their response through in-game cues, such as changes in their stance or willingness to engage in trade. Gradually escalate the value of your offerings as trust builds, but always ensure your own empire remains stable—depleting your resources for the sake of an alliance can leave you vulnerable to other threats.
In conclusion, using gifts to befriend the Grox is a delicate art, blending resource management with psychological insight. It’s not merely about what you give, but how and when you give it. Master this strategy, and you’ll transform the galaxy’s most feared empire into a powerful ally, proving that even the Grox have a price—one paid not in credits, but in thoughtful generosity.
Should You Download All Spore DLC? A Comprehensive Guide
You may want to see also

Non-Aggressive Stance: Avoid attacking or provoking them to maintain peaceful relations
In the intricate dance of interstellar diplomacy within *Spore*, the Grox are often perceived as an insurmountable obstacle due to their aggressive nature and territorial dominance. However, adopting a non-aggressive stance can transform this challenge into an opportunity for alliance. The key lies in understanding that the Grox, like any other species, respond to actions more than intentions. Provoking them through attacks or encroachment on their space will only solidify their hostility, making friendship impossible. Instead, prioritize restraint and respect for their boundaries, allowing them to perceive you as a non-threat.
Analyzing the Grox’s behavior reveals a pattern: they are less likely to initiate conflict if you avoid direct confrontation. This means refraining from attacking their colonies, ships, or even straying too close to their controlled systems. While it may be tempting to test their limits, such actions will only reinforce their defensive mechanisms. By maintaining a safe distance and focusing on your own expansion in unclaimed territories, you signal that you are not a competitor for their resources or dominance. This passive approach lays the groundwork for eventual trust, as the Grox begin to recognize your species as neutral rather than hostile.
To operationalize this strategy, follow these steps: first, map out Grox-controlled systems and mark them as no-go zones. Second, redirect your exploration and colonization efforts toward unoccupied regions, ensuring minimal overlap with their territory. Third, equip your ships with non-combative tools, such as terraforming devices or trade modules, to emphasize peaceful intentions. Finally, monitor their reactions over time; if they cease aggressive patrols near your borders, it’s a sign that your non-aggressive stance is working. Patience is critical, as building trust with the Grox is a gradual process that requires consistency in your actions.
A comparative analysis highlights the effectiveness of this approach. Players who adopt aggressive strategies often find themselves locked in endless wars with the Grox, draining resources and stunting their civilization’s growth. In contrast, those who prioritize peace report eventual alliances, with the Grox even defending their territories from other threats. This shift occurs because the Grox interpret non-aggression as a sign of respect for their power, aligning with their hierarchical worldview. By mirroring their behavior—dominance without direct challenge—you position yourself as a worthy ally rather than a disposable foe.
In practice, maintaining a non-aggressive stance requires discipline and foresight. Avoid the temptation to retaliate even if the Grox test your resolve with minor skirmishes. Instead, retreat and reassess your strategy, ensuring no further provocations occur. Over time, this approach not only preserves your resources but also opens doors to diplomatic interactions, such as trading or joint defense pacts. Befriending the Grox through non-aggression is not about weakness; it’s a calculated strategy that leverages their psychology to turn a formidable adversary into a powerful ally.
Understanding the Size of Black Mold Spores: A Comprehensive Guide
You may want to see also

Diplomatic Tools: Use the Befriend or Ally options in the game interface effectively
In *Spore*, befriending the Grox—the galaxy’s notoriously hostile empire—requires strategic use of the game’s diplomatic tools. The Befriend and Ally options in the interface are your primary instruments, but their effectiveness hinges on timing, preparation, and understanding the Grox’s behavior. Unlike other empires, the Grox demand respect and strength, so approaching them with a low empire score or weak fleet will likely end in war. Before initiating diplomacy, ensure your empire is robust enough to command their attention.
The Befriend option is your first step, but it’s not a one-click solution. Start by sending a gift of spice, a resource the Grox value. However, the amount matters—a small offering may be seen as an insult, while a substantial gift (500–1000 spice) signals respect and seriousness. Pair this with a Trade Route request to establish economic ties, which can gradually improve relations. If the Grox accept, it’s a sign they’re open to further negotiation. If they refuse, back off temporarily and focus on strengthening your empire before trying again.
Once befriended, the Ally option becomes available, but it’s a delicate maneuver. The Grox are unpredictable, and becoming their ally can provoke other empires into declaring war on you. To mitigate this, maintain neutral or friendly relations with neighboring empires while pursuing the alliance. Use the Bribe tool to sway empires that turn hostile, buying time to consolidate your position. Remember, allying with the Grox grants access to their advanced technology and protects you from their aggression, but it’s a high-risk, high-reward strategy.
A critical caution: the Grox’s mood can shift abruptly, especially if they perceive weakness. Always keep a strong fleet near their borders and avoid colonizing planets too close to their territory. If relations sour, use the Apologize option immediately, but be prepared to defend yourself if they attack. Diplomacy with the Grox is a balancing act—one misstep can undo hours of progress.
In conclusion, mastering the Befriend and Ally tools with the Grox requires patience, resource management, and strategic foresight. Approach them with respect, strength, and caution, and you may turn the galaxy’s most fearsome empire into a powerful ally. Fail to prepare, and you’ll become another victim of their wrath.
Are Psilocybe Cubensis Spores Illegal in Florida? Legal Insights
You may want to see also

Alliance Benefits: Leverage Grox alliances for protection and access to their territories
In the vast universe of Spore, the Grox are a formidable force, often feared for their aggressive nature and expansive territories. However, forming an alliance with them can turn their might into a powerful asset. By leveraging Grox alliances, players can gain unparalleled protection and access to otherwise restricted regions, significantly enhancing their galactic influence.
To initiate such an alliance, diplomacy is key. Start by identifying Grox-controlled systems and sending emissaries to establish communication. Gifts of valuable resources or technology can soften their stance, but consistency is crucial. Regularly engaging in peaceful interactions builds trust over time. Once an alliance is secured, the Grox will defend your empire against hostile factions, effectively deterring potential invaders. This protective umbrella allows players to focus on expansion and development without constant fear of attack.
Access to Grox territories is another significant benefit. These territories often contain rare resources, unique artifacts, and strategic locations. With their permission, players can explore and exploit these areas, gaining a competitive edge in resource management and technological advancement. For instance, mining operations in Grox-controlled asteroid belts can yield exotic minerals essential for advanced spacecraft construction. Additionally, establishing trade routes through their space can streamline resource distribution across your empire.
However, maintaining a Grox alliance requires vigilance. The Grox are unpredictable, and any perceived betrayal can lead to swift retaliation. Players must avoid actions that might provoke them, such as encroaching on their core systems or allying with their enemies. Regularly monitoring their diplomatic stance and addressing grievances promptly can prevent misunderstandings. It’s also wise to maintain a strong military presence as a deterrent, ensuring the Grox respect the alliance rather than exploit it.
In conclusion, allying with the Grox in Spore offers substantial benefits, from robust protection to exclusive access to their territories. While the process demands careful diplomacy and constant vigilance, the rewards far outweigh the risks. By mastering this alliance, players can dominate the galaxy, turning the Grox from a threat into an invaluable partner.
Can E. Coli Form Spores? Unraveling the Bacterial Survival Myth
You may want to see also
Frequently asked questions
To befriend the Grox, you must first locate their empire on the galactic map. Approach their territory cautiously, as they are initially hostile. Use the "Greet" interaction to initiate communication, but be prepared for a negative response.
The Grox are known for their aggressive nature, so building trust is crucial. Try offering gifts, such as spices or rare artifacts, to show goodwill. Completing quests for them or aiding in their battles against other empires can also significantly improve relations.
Yes, it is possible to form an alliance with the Grox, but it requires significant effort and a high relationship status. Allied with the Grox grants you access to their advanced technology, powerful military support, and increased influence in the galaxy, making it a valuable but challenging endeavor.